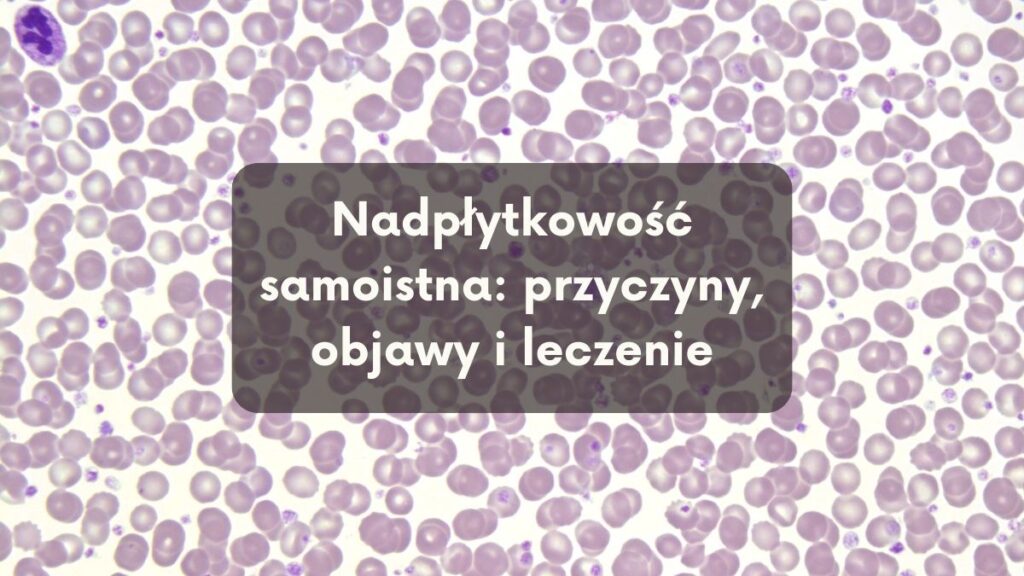
Nadpłytkowość samoistna: przyczyny, objawy i leczenie

I. Wstęp
A. Czym jest nadpłytkowość samoistna?
Definicja i podstawowe informacje
Nadpłytkowość samoistna, znana również jako essential thrombocythemia (ET), to przewlekła choroba krwi charakteryzująca się nadmierną produkcją płytek krwi przez szpik kostny. Płytki krwi, niewielkie fragmenty komórek, odgrywają kluczową rolę w procesie krzepnięcia krwi.

Dlaczego temat jest ważny?
Nadpłytkowość samoistna może prowadzić do poważnych powikłań, takich jak nadmierny krzepnięcie krwi (zakrzepy) lub skłonność do krwawień. Dlatego ważne jest zrozumienie tej choroby, aby zapewnić odpowiednie leczenie i monitorowanie stanu zdrowia pacjenta.
B. Znaczenie wczesnej diagnozy i leczenia
Wczesna diagnoza nadpłytkowości samoistnej jest kluczowa dla skutecznego leczenia i zapobiegania powikłaniom. Dzięki szybkiej identyfikacji choroby istnieje możliwość wdrożenia odpowiednich terapii mających na celu kontrolę nad liczbą płytek krwi oraz minimalizację ryzyka zakrzepów i krwotoków. Regularna opieka lekarska i śledzenie stanu pacjenta pomagają utrzymać chorobę pod kontrolą i poprawić jakość życia osoby z nadpłytkowością samoistną.
II. Zrozumienie nadpłytkowości samoistnej
A. Co to są płytki krwi?
Funkcje i rola w organizmie:
Płytki krwi, zwane również trombocytami, są niewielkimi fragmentami komórek odpowiedzialnymi za proces krzepnięcia krwi. Ich główną funkcją jest zapewnienie zapobiegania nadmiernemu krwawieniu poprzez tworzenie skrzepów krwi w miejscach uszkodzeń naczyń krwionośnych. Płytki pełnią więc kluczową rolę w utrzymaniu homeostazy organizmu poprzez kontrolę krzepnięcia i krwawienia.
B. Różnica między nadpłytkowością samoistną a innymi typami nadpłytkowości
Nadpłytkowość reaktywna vs samoistna:
Nadpłytkowość reaktywna jest stanem, w którym ilość płytek krwi wzrasta w odpowiedzi na inne czynniki, takie jak stan zapalny, infekcja lub choroba nowotworowa. Z kolei nadpłytkowość samoistna jest schorzeniem, w którym nadmierna produkcja płytek jest wynikiem zaburzenia szpiku kostnego, niezależnie od zewnętrznych czynników.
Istotną różnicą między tymi dwoma rodzajami nadpłytkowości jest ich podłoże etiologiczne, co wpływa na proces diagnozowania, leczenia i monitorowania pacjenta z tą chorobą. Dlatego ważne jest właściwe rozróżnienie pomiędzy nadpłytkowością reaktywną a samoistną w celu ustalenia odpowiednich strategii terapeutycznych.
III. Przyczyny nadpłytkowości samoistnej
A. Mutacje genetyczne i ich rola
Mutacja JAK2, CALR, MPL:
Nadpłytkowość samoistna może być spowodowana mutacjami genetycznymi, które wpływają na produkcję lub funkcjonowanie płytek krwi. Mutacje w genach JAK2, CALR i MPL są szczególnie istotne w kontekście nadpłytkowości samoistnej. Mutacja w genie JAK2 (Janus kinaza 2) jest jednym z najczęstszych czynników prowadzących do nadpłytkowości samoistnej, a także innych schorzeń mieloproliferacyjnych. Natomiast mutacje w genach CALR (kalretulina) i MPL (receptor trombopoetyny) również są powiązane z nadpłytkowością samoistną, chociaż w mniejszym stopniu.
B. Czynniki środowiskowe i ich znaczenie
Czynniki środowiskowe i ich znaczenie:
Pomimo dominującej roli mutacji genetycznych, istnieje również możliwość wpływu czynników środowiskowych na rozwój nadpłytkowości samoistnej. Niektóre badania wskazują na potencjalne związki między ekspozycją na substancje chemiczne, promieniowanie jonizujące, infekcje wirusowe oraz inny stres środowiskowy a zwiększonym ryzykiem rozwoju nadpłytkowości samoistnej. Jednak pełny zakres wpływu czynników środowiskowych na rozwój tej choroby nadal pozostaje przedmiotem badań i nie jest w pełni poznany.
Zrozumienie zarówno genetycznych, jak i środowiskowych przyczyn nadpłytkowości samoistnej jest kluczowe dla skutecznego diagnozowania, leczenia i zarządzania tym schorzeniem, a także dla rozwoju bardziej spersonalizowanych strategii terapeutycznych.
IV. Objawy nadpłytkowości samoistnej
A. Typowe objawy
Zmęczenie, bóle głowy, krwawienia:
Nadpłytkowość samoistna może objawiać się różnymi dolegliwościami, w tym złym samopoczuciem, intensywnym zmęczeniem oraz bólami głowy. Jednak jednym z najbardziej charakterystycznych objawów tej choroby są krwawienia. Pacjenci z nadpłytkowością samoistną mogą doświadczać krwawień z nosa, dziąseł, siniaków czy krwiomoczu. Zwiększone ryzyko krwawień wynika z nadmiernego gromadzenia się płytek krwi w naczyniach krwionośnych.
B. Objawy poważnych powikłań
Zakrzepy, krwotoki, uszkodzenie narządów:
Oprócz typowych objawów, nadpłytkowość samoistna może prowadzić do poważnych powikłań. Jednym z nich są zakrzepy – zaburzenia w przepływie krwi, które mogą prowadzić do skrzepów krwi.
- Zakrzepy mogą wystąpić w naczyniach krwionośnych, co zwiększa ryzyko wystąpienia udaru mózgu, zatorowości płucnej lub zakrzepicy żył głębokich.
- Z drugiej strony, nadpłytkowość samoistna może również predysponować pacjentów do krwotoków, które mogą być groźne dla życia.
- Ponadto, niekontrolowana nadpłytkowość może prowadzić do uszkodzenia narządów w wyniku niedotlenienia spowodowanego zakrzepami lub krwotokami.
Zrozumienie objawów nadpłytkowości samoistnej, zarówno typowych, jak i poważnych powikłań, jest istotne dla szybkiej diagnozy, leczenia i kontrolowania tej choroby krwi. Pacjenci z nadpłytkowością samoistną powinni regularnie monitorować swoje objawy i skonsultować się z lekarzem w przypadku jakichkolwiek niepokojących zmian w samopoczuciu czy pojawienia się nowych objawów.
V. Diagnoza nadpłytkowości samoistnej
A. Podstawowe badania diagnostyczne
- Morfologia krwi: Podstawowym badaniem diagnostycznym stosowanym w przypadku podejrzenia nadpłytkowości samoistnej jest morfologia krwi. Badanie to pozwala ocenić liczbę płytek krwi w organizmie pacjenta. Niedobór liczby płytek krwi może wskazywać na możliwą nadpłytkowość.
- Badania genetyczne: W celu potwierdzenia diagnozy nadpłytkowości samoistnej, lekarz może zalecić badania genetyczne. Analiza genetyczna może pomóc zidentyfikować specyficzne mutacje genów związanych z nadpłytkowością samoistną, co może być istotne dla ustalenia dokładnego rodzaju choroby oraz sposobu postępowania terapeutycznego.
B. Kryteria rozpoznania WHO
Kryteria rozpoznania nadpłytkowości samoistnej ustalone przez Światową Organizację Zdrowia (WHO) mogą obejmować odpowiednie parametry laboratoryjne, obecność charakterystycznych objawów klinicznych oraz wykluczenie innych zakrzepowo-zatorowych schorzeń krwi. Ustalenie diagnozy zgodnie z kryteriami WHO jest istotne dla właściwego zarządzania chorobą i podejmowania odpowiednich działań terapeutycznych.
C. Rola specjalistów w procesie diagnostycznym
W procesie diagnozy nadpłytkowości samoistnej mogą brać udział różni specjaliści, w zależności od potrzeb pacjenta. Do diagnostyki nadpłytkowości mogą być zaangażowani hematolodzy, specjaliści od diagnostyki genetycznej oraz lekarze laboratoryjni. Hematolog może przeprowadzić ocenę kliniczną pacjenta i zlecić odpowiednie badania laboratoryjne. Specjalista od badań genetycznych może przeprowadzić analizę DNA w celu identyfikacji genetycznych przyczyn nadpłytkowości. Lekarze laboratoryjni pełnią kluczową rolę w wykonywaniu i interpretacji wyników badań poprzez analizę próbek krwi pacjenta.
Diagnoza nadpłytkowości samoistnej wymaga zespołowego podejścia z udziałem różnych specjalistów, aby zapewnić kompleksową ocenę stanu pacjenta i właściwe zarządzanie jego chorobą.
VI. Leczenie nadpłytkowości samoistnej
A. Cele leczenia
- Zapobieganie powikłaniom: Głównym celem leczenia nadpłytkowości samoistnej jest zapobieganie powikłaniom związanym z nadmiarem płytek krwi, takim jak zakrzepica. Kontrola nad liczbą płytek krwi ma kluczowe znaczenie dla minimalizowania ryzyka wystąpienia powikłań związanych z chorobą.
- Kontrola liczby płytek: Ważnym aspektem terapii nadpłytkowości jest monitorowanie i kontrola liczby płytek krwi u pacjenta. Regularne badania krwi pozwalają na monitorowanie skuteczności leczenia oraz dostosowywanie terapii w zależności od poziomu płytek.
B. Opcje farmakologiczne
- Hydroksymocznik: Hydroksymocznik jest jednym z leków często stosowanych w leczeniu nadpłytkowości samoistnej. Działa poprzez zmniejszenie produkcji płytek krwi w szpiku kostnym, co pomaga kontrolować nadmierną liczbę płytek.
- Anagrelid: Anagrelid to kolejny lek stosowany w terapii nadpłytkowości. Jego działanie polega na hamowaniu produkcji płytek krwi i zmniejszeniu aktywności płytek, co przyczynia się do regulacji liczby płytek we krwi.
- Interferon alfa: Interferon alfa jest czasami również wykorzystywany w leczeniu nadpłytkowości samoistnej. Lek ten działa poprzez regulację układu immunologicznego oraz hamowanie produkcji nadmiernych płytek.
C. Nieinwazyjne metody leczenia
Zmiana stylu życia może również mieć pozytywny wpływ na przebieg nadpłytkowości samoistnej. Regularna aktywność fizyczna, unikanie palenia papierosów, ograniczenie spożycia alkoholu oraz zdrowa dieta mogą wspomóc leczenie i kontrolę choroby.
D. Rola flebotomii w terapii
Flebotomia, czyli procedura usuwania nadmiaru krwi, może być stosowana w leczeniu nadpłytkowości samoistnej. Poprzez pobieranie krwi pacjentowi można efektywnie kontrolować liczbę płytek krwi, co przyczynia się do zmniejszenia ryzyka powikłań związanych z nadmiarem płytek. Flebotomia może być skuteczną metodą terapeutyczną szczególnie u pacjentów, u których inne opcje terapeutyczne nie przynoszą oczekiwanych rezultatów.
Kompleksowe podejście terapeutyczne, uwzględniające zarówno farmakoterapię, jak i zmiany stylu życia oraz procedury takie jak flebotomia, może być kluczowe dla skutecznego leczenia nadpłytkowości samoistnej i zapobiegania powikłaniom z nią związanym.
VII. Powikłania nadpłytkowości samoistnej
A. Zakrzepy i ich konsekwencj
- Udar mózgu: Nadmiar płytek krwi może prowadzić do powstania skrzepów, które mogą zablokować przepływ krwi w mózgu, powodując udar mózgu.
- Zawał serca: Podobnie jak w przypadku udaru mózgu, zakrzepy mogą blokować naczynia krwionośne w obrębie serca, prowadząc do zawału serca.
- Zatorowość płucna: Skrzepy tworzące się w naczyniach krwionośnych mogą przedostać się do płuc i spowodować zatorowość płucną, co może być groźne dla życia.
B. Krwotoki – dlaczego się zdarzają?
- Mechanizmy związane z zaburzeniem funkcji płytek: W przypadku nadpłytkowości samoistnej występuje zmniejszona liczba płytek krwi, co może prowadzić do skłonności do krwawień i występowania krwotoków. Zaburzenie funkcji płytek uniemożliwia im skuteczne tworzenie skrzepów krwi, co zwiększa ryzyko krwotoków.
C. Transformacja w inne choroby mieloproliferacyjne
- Włóknienie szpiku: Nadpłytkowość samoistna może być związana z rozwojem włóknienia szpiku kostnego, co prowadzi do zmniejszonej produkcji komórek krwi w szpiku.
- Ostra białaczka szpikowa: W niektórych przypadkach nadpłytkowość samoistna może przejść w ostrą białaczkę szpikową, co stanowi poważne schorzenie związane z nadmierną produkcją komórek krwi.
VIII. Styl życia z nadpłytkowością samoistną
A. Znaczenie diety i aktywności fizycznej
- Dobór odpowiedniej diety: Osoby z nadpłytkowością samoistną powinny stosować zrównoważoną dietę bogatą w warzywa, owoce, pełnoziarniste produkty zbożowe oraz zdrowe tłuszcze, których składniki mogą wspomagać zdrowie krwi i układu krwionośnego.
- Unikanie kontuzji: W przypadku nadpłytkowości samoistnej istnieje większe ryzyko krwawień, dlatego ważne jest unikanie intensywnych aktywności fizycznych i sportów kontaktowych, które mogą zwiększać ryzyko urazów i krwawień.
B. Radzenie sobie ze stresem i emocjami
- Techniki relaksacyjne: Osoby z nadpłytkowością samoistną mogą skorzystać z technik relaksacyjnych, takich jak medytacja, joga, czy głębokie oddychanie, które pomagają w utrzymaniu równowagi emocjonalnej i redukowaniu stresu.
- Wsparcie psychologiczne: Współpraca z terapeutą może pomóc osobom z nadpłytkowością samoistną w radzeniu sobie ze stresem i negatywnymi emocjami związanymi z chorobą.
C. Wsparcie psychologiczne i grupy wsparcia
- Wsparcie bliskich: Wsparcie ze strony rodziny i przyjaciół odgrywa kluczową rolę w radzeniu sobie z chorobą. Zrozumienie i wsparcie bliskich może pomóc w utrzymaniu pozytywnego stanu emocjonalnego.
- Grupy wsparcia: Dołączenie do grupy wsparcia dla osób z nadpłytkowością samoistną może być bardzo pomocne, umożliwiając dzielenie się doświadczeniami z innymi osobami dotkniętymi tą chorobą i zdobywanie cennych porad od innych pacjentów.
IX. Postępy w badaniach i innowacje w leczeniu
A. Nowe terapie i badania kliniczne
- Badania nad terapiami celowanymi: Naukowcy prowadzą wiele badań w celu opracowania terapii celowanych w leczeniu nadpłytkowości samoistnej. Poszukiwane są substancje, które mogą zwiększyć liczbę płytek krwi lub poprawić funkcję układu odpornościowego.
- Wykorzystanie terapii immunomodulacyjnych: Badania kliniczne skupiają się także na zastosowaniu terapii immunomodulacyjnych w leczeniu ITP. Próbuje się opracować metody regulacji odpowiedzi autoimmunologicznej, aby kontrolować niszczenie płytek krwi przez organizm.
B. Rola medycyny spersonalizowanej
- Identyfikacja predyspozycji genetycznych: Medycyna spersonalizowana bada predyspozycje genetyczne jednostek do rozwoju nadpłytkowości samoistnej. Dzięki identyfikacji konkretnych czynników genetycznych możliwe jest lepsze zrozumienie choroby i opracowanie spersonalizowanych strategii leczenia.
- Dostosowanie terapii do pacjenta: Medycyna spersonalizowana umożliwia dobranie optymalnej terapii do indywidualnych potrzeb i cech pacjenta. Dzięki temu leczenie może być bardziej skuteczne i mniej inwazyjne, minimalizując ryzyko działań niepożądanych.
Wyniki badań naukowych i rozwój medycyny spersonalizowanej mają potencjał przyniesienia nowych, skuteczniejszych terapii dla pacjentów z nadpłytkowością samoistną. Kontynuacja prac badawczych pozwoli na dalsze zrozumienie tej choroby i poprawę skuteczności leczenia.
X. Podsumowanie nadpłytkowości samoistnej
A. Kluczowe wnioski i wskazówki dla pacjentów
- Regularne kontrole lekarskie: Pacjenci z nadpłytkowością samoistną powinni regularnie uczestniczyć w kontroli u lekarza specjalizującego się w hematologii lub immunologii. Regularne badania krwi są kluczowe dla monitorowania poziomu płytek i skuteczności leczenia oraz zapobiegania powikłaniom.
- Zachowanie ostrożności w przypadku urazów: Ze względu na tendencję do krwawień i siniaków, pacjenci z ITP powinni zachować ostrożność w przypadku urazów i unikać sytuacji, które mogą prowadzić do obrażeń. Należy unikać aktywności fizycznej, która może zwiększyć ryzyko urazów.
- Skuteczna komunikacja z zespołem medycznym: Ważne jest, aby pacjenci z nadpłytkowością samoistną mieli otwartą i skuteczną komunikację z zespołem medycznym. Pacjenci powinni informować lekarzy o wszelkich zmianach w swoim stanie zdrowia, skuteczności leczenia oraz występowaniu skutków ubocznych terapii.
- Edukacja pacjentów: Kluczowym elementem zarządzania nadpłytkowością samoistną jest edukacja pacjentów na temat choroby, jej objawów, leczenia oraz zaleceń dotyczących stylu życia. Pacjenci powinni być świadomi swojej choroby, umieć rozpoznać objawy zaostrzenia i wiedzieć, jak postępować w sytuacji nagłego pogorszenia stanu zdrowia.
Podsumowując, skuteczne zarządzanie nadpłytkowością samoistną wymaga regularnych kontroli lekarskich, umiejętności zapobiegania urazom, skutecznej komunikacji z zespołem medycznym oraz edukacji pacjentów.
Oczywiście! Oto rozszerzone odpowiedzi na najczęściej zadawane pytania dotyczące nadpłytkowości samoistnej:
XI. Najczęściej zadawane pytania (FAQ)
A. Czy nadpłytkowość samoistna zawsze wymaga leczenia?
Nadpłytkowość samoistna nie zawsze wymaga leczenia, zwłaszcza w łagodnych przypadkach, w których pacjent nie wykazuje poważnych objawów ani nie ma ryzyka groźnych powikłań. Jednak w przypadkach, gdy poziom płytek krwi jest zbyt niski lub pojawiają się wymagające interwencji objawy, może być konieczne leczenie, aby zapobiec powikłaniom.
B. Jakie są szanse na całkowite wyleczenie?
Niestety, nadpłytkowość samoistna jest zazwyczaj chorobą przewlekłą i często nie prowadzi do całkowitego wyleczenia. W większości przypadków celem terapii jest kontrola objawów, utrzymanie odpowiedniego poziomu płytek krwi i zapobieganie powikłaniom. Jednak w niektórych przypadkach może dojść do spontanicznej remisji.
C. Czy można zapobiec powikłaniom?
Zapobieganie powikłaniom związanych z nadpłytkowością samoistną polega głównie na monitorowaniu poziomu płytek krwi, regularnym leczeniu według zaleceń lekarza oraz unikaniu czynników, które mogą zwiększać ryzyko krwawień. W razie pojawienia się krwawień, siniaków lub innych nietypowych objawów, należy natychmiast skontaktować się z lekarzem.
D. Jakie są możliwe skutki uboczne leków?
Skutki uboczne leków stosowanych w leczeniu nadpłytkowości samoistnej mogą się różnić w zależności od rodzaju terapii. Niektóre leki mogą powodować problemy żołądkowe, zmiany w krzepliwości krwi, nadciśnienie lub inne objawy. Dlatego ważne jest regularne monitorowanie pacjenta podczas leczenia i informowanie lekarza o wszelkich nieprzewidzianych reakcjach organizmu.
Zioła w leczeniu chorób: Nadpłytkowość samoistna
Oto kilka ziół, które mogą być pomocne w leczeniu nadpłytkowości samoistnej:
- Miłorząb japoński: Roślina ta ma potencjalne działanie przeciwpłytkowe, co może pomóc w zmniejszeniu agregacji płytek.
- Czosnek: Znany ze swoich właściwości przeciwpłytkowych i przeciwzakrzepowych, czosnek może mieć wpływ na kontrolowanie nadmiernego wytwarzania płytek krwi.
- Imbir: Wykazuje działanie przeciwpłytkowe i przeciwzapalne, co może być korzystne w kontekście nadpłytkowości samoistnej.
Warto jednak pamiętać, że przed zastosowaniem tych ziół w leczeniu nadpłytkowości ważne jest skonsultowanie się z lekarzem. Ponadto należy używać ich ostrożnie, szczególnie jeśli osoba przyjmuje leki przeciwkrzepliwe, aby uniknąć potencjalnych interakcji.